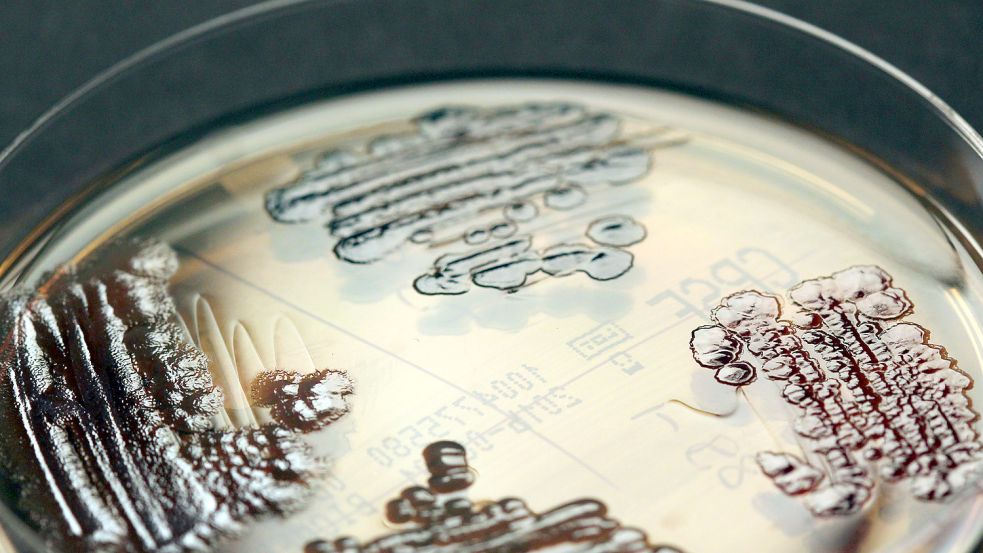

Berlin Warum sich immer mehr Pharmakonzerne aus der Antibiotika-Forschung zurückziehen

Multiresistente Keime nehmen zu und Antibiotika wirken nicht. Foto: picture alliance / dpa / IMMIH, Köln
Die unscheinbare Pandemie der multiresistenten Keime breitet sich immer weiter aus. Die Medizin braucht neue Antibiotika, um sie zu stoppen. Doch Pharmakonzerne haben sich aus der Forschung zurückgezogen.
Lesedauer des Artikels: ca. 2 Minuten
Jetzt Artikel freischalten
Schnell bestellt – jederzeit kündbar.
- Voller Zugriff auf on-online.de
- 700+ neue Artikel pro Woche
- ON-App inklusive
3 Monate je
1€
statt 9,90 €
Du hast bereits ein ON-Abo? Super!
Weitere Abo-Modelle